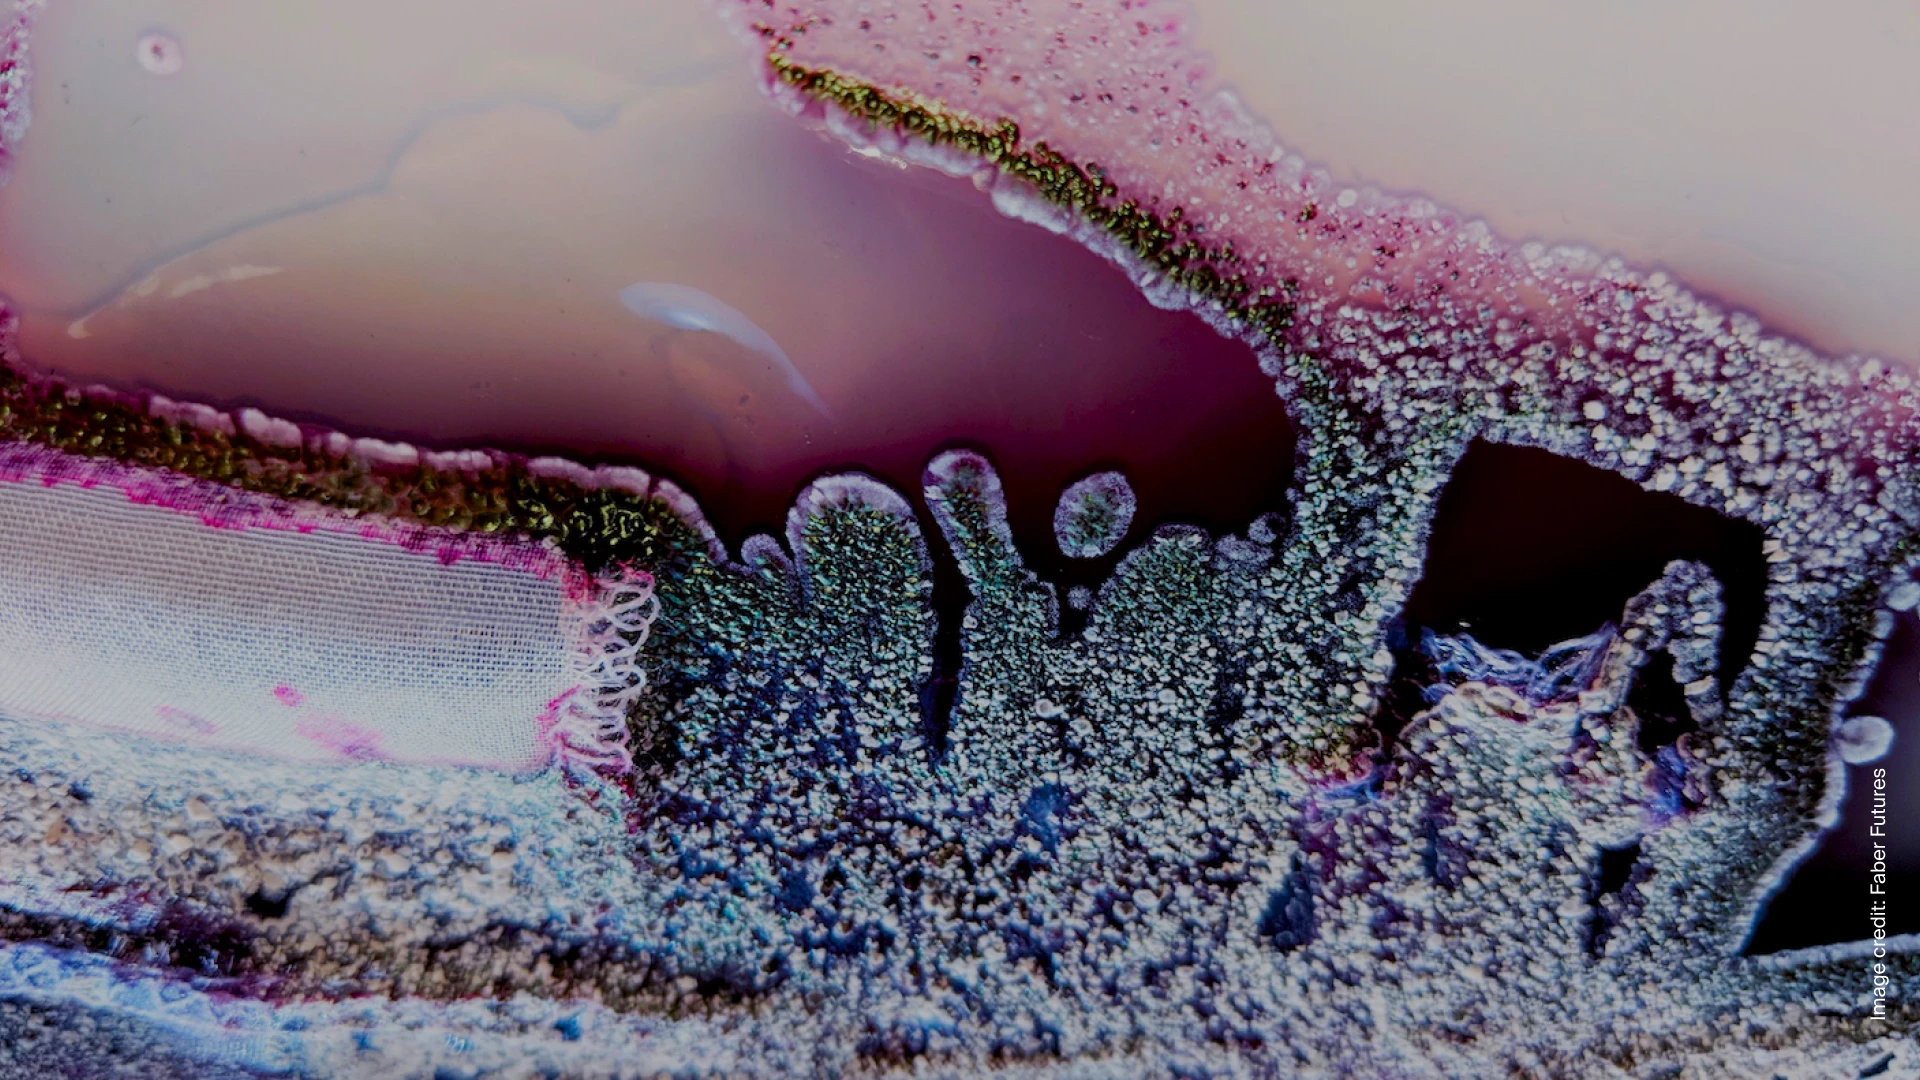

Touring the Atomic Farm: Deep tech & The 4IR
This week at the House we sat down with Massimo Portincaso, founder of Deepwave Ventures, chairman of Hello Tomorrow—the leading platform for Deep Tech-powered changemaking—and author of The Antidisciplinarian, a weekly newsletter at the intersection of science, tech, and business, to talk deep. Deep Tech, by its very nature, is mind-blowing, encompassing the edges of scientific development in biology, chemistry, electronics, engineering, finance, and health—and the convergence of all of the above. The potential for change that these technologies promise is staggering. “We are in the midst of a major societal transformation,” Massimo told us, “comparable to our transition from hunters to farmers over 10,000 years ago. This time, it’s a shift from the exploitative paradigm that marked the first and second Industrial Revolutions to a more generative one. In the Fourth Industrial Revolution, or 4IR, we’re beginning to co-design with nature at an atomic level. Call us atomic farmers.”
Let’s tour the atomic farm.
Milk without mammal
Dairy farming has been estimated to contribute some 1,969 million tons of carbon to the atmosphere every year. Organic dairies aren’t much better, because cows still fart. Plant-based milks have gained a huge amount of market share in recent years, with the total market projected to reach $40.6 billion by 2026. But if you’ve ever tried a plant-based cheese, you know it’s no substitute for mozzarella. And no soy- or coconut-based alternative to ice cream tastes as creamy or as good. Unless, perhaps, it’s made with microbes.
“Dairy tastes like dairy thanks to two key proteins, casein and whey protein,” writes Knvul Sheikh in the New York Times. Researchers at several startups are now producing these proteins in the lab. “Microbes, such as yeast, are given the genetic instructions to produce the dairy proteins. The microbes are then cultivated en masse, with nutrients added and the temperature adjusted.” Like the molecule called heme that’s found abundantly in meat, and is now grown in a lab to give the Impossible Burger its meat-like taste, lab-grown dairy proteins promise to make vegan milks and cheeses rival the real thing.
Cell-cultured human milk is also now on the horizon. North Carolina startup BIOMILQ is cultivating human mammary cells that lactate, producing milk with nutrient profiles that closely resemble the real thing. Other startups are using components like algae, bacteria, fungi, and yeast to bioengineer components of human milk like lactoferrin or human milk oligosaccharides, some of which are already on the market. Whole milk that is close to being bioidentical to human milk may be on the shelves soon.

Photo by Engin Akyurt: Milk
Palm oil without the palm oil farm
Found in 50 percent of all packaged products—from doughnuts to toothpaste, deodorant, and shampoo—palm oil is a major driver of global deforestation. Startup c16 Biosciences uses fermentation to brew a sustainable alternative from microbes, promising a product that performs better and is cost-competitive with conventional palm oil, minus the existential threat to elephants, rhinos, and orangutans.
Collagen, too, can be brewed rather than harvested. Estimated to be a $22.6 billion market by 2027, collagen is widely used in cosmetics, and is conventionally sourced from the bones, tendons, and skin of animals—even from human foreskins. Cosmetics startup Geltor has found a way to brew human-identical collagen, and offers brands and manufacturers the opportunity to generate bespoke proteins using their “proprietary computational biology platform.”
Brewing is also a solution for waste. Startups like LanzaTech and Mango Materials use waste as foundational materials, co-locating their production facilities where waste is produced. LanzaTech works to convert CO2 to ethanol using a gas-fermentation process that employs hydrogen, an affordable and renewable resource. Mango Materials harnesses bacteria to brew methane into a polymer that can be incorporated into conventional plastic supply chains.
As Massimo Portincaso explains in “Nature Co-Design,” a paper he published with Hello Tomorrow and the Boston Consulting Group, biotechnologies promise ways to farm atoms that beg comprehension—and to add “some $100 trillion to the global economy by 2040.”
Robots, bismuth, and data stored in DNA
“Just as humans have been selectively breeding crops since the dawn of farming,” writes Emma Hart in The Guardian, “the robot breeder could influence selection of robots with particular traits.” Does this mean that robots might independently reproduce? While robot farms may not yet be on their way, scientists are applying evolutionary methods to robot breeding. As Hart explains, “New generations can be produced from a union of the most successful traits from a virtual ‘mother’ and a physical ‘father,’ combining the benefits of fast but potentially unrealistic simulated evolution with the more accurate assessment of robots in a real physical environment. The new robots therefore inherit traits that represent the best of both types of evolution.”
Deep Tech’s range is breathtakingly vast. Bismuth, the brittle metal best known as the active ingredient in Pepto Bismol, could be leveraged to power your electronics. The field of biomimetics, too, is advancing rapidly, from bacteria-based, self-healing concrete to water-repellent solutions inspired by the hydrophobic properties of the lotus plant. And then there’s the promise of data storage in DNA: DNA has phenomenal data densities compared to most other media. If stored in the right conditions, DNA requires no energy to maintain data for centuries. A team from MIT and the Broad Institute has created a new DNA-based image-storage system, though queries can still take days to process.

Photo by National Cancer Institute: Three-dimensional landscape of genome
Human farms and GMOs
It’s not only human mammary cells that scientists have learned how to farm. In 2018, in what was called a first for regenerative medicine, five children received new ears generated using their own cells. Now a team at Harvard University is seeking approval for a 3D-printed biomimetic graft of human eardrum tissue that promises to enable damaged eardrums to heal themselves.
But the biggest contribution of Deep Tech to human health may come in the form of medications, not lab-grown body parts. Pharmaceutical startup Antheia, for example, is making hyoscyamine, an anti-nausea drug, and scopolamine, a drug used in the treatment of irritable bowel syndrome and Parkinson’s disease, by modifying the DNA of everyday yeast.
Which leads us to an important question: Is genetic engineering OK?
The Green Party in Germany has long been opposed to GMOs, citing the risks and unknowns associated with growing and consuming genetically modified foods. Resistance to GMOs is widespread—19 out of 27 EU member states have banned them—but, at least among the Greens in Germany, that opposition may be about to change. After the European Commission published a study in April concluding that the laws regarding new genomic technologies are “insufficient,” two party leaders published a paper acknowledging the potential benefits of genetic engineering.
As climate change threatens the global food supply, the need for genetically modified crops is becoming urgent, to say nothing of the promise that genetic engineering holds for human health and the environment. Last month a Green Member of the European Parliament warned that current regulations against genetic engineering are a threat to innovation within the EU. But even if regulations are lifted, will the public embrace things like synthetic biology? Or will fear of genetic engineering become as widespread as the global hesitancy surrounding vaccines?
Deep Tech and the arts
As Massimo Portincaso told us last week, the key to public acceptance of some of the more shocking developments in the world of Deep Tech is the arts. “One of the roles of art is to push the boundary, and make things that look ‘far out’ more tangible and realistic.” Art, he said, translates the unexplainable into our cultural contexts, making new things less frightening, and making the future seem more like the now.
Perhaps not surprisingly, art and design are where new technologies are creating some truly incredible things.

Photo by Officina Corpuscoli: Mogu
Mushrooms in Amsterdam
No, not those kinds of mushrooms. Maurizio Montalti, founder at industrial bio-fabrication firm Mogu, set out to make “the first company to offer commercial mycelium-based products on the market, suitable for interior design applications and as an alternative to traditional synthetic materials, such as petroleum-based plastics.” At his studio Officina Corpuscoli, scientists work alongside designers.
Coming to terms with the implications of Deep Tech, Montalti believes, will entail not just a confrontation with ethics, mortality, and public skepticism, but entertaining the possibility that this is all part of fungi’s quest for world domination:
“What if the fungi have a hidden plan, and they have been working it out for millions of years?”
You can read Massimo Portincaso’s interview with him here, and watch a video about Montalti's work here.
Microorganisms at MIT
Artist, engineer, and founder at MIT Media Lab’s Mediated Matter group, Neri Oxman sees a shift from consuming nature as a geological resource to editing it as a biological one. In a 2016 article for the World Economic Forum, she writes how microorganism factories could grow rather than assemble. One of Oxman’s most interesting ideas is the Krebs Cycle of Creativity, where the four modalities of human creativity—science, engineering, design, and art—produce currency by transforming into another. Watch a video about Oxman’s work here.
Bacteria in London
Biodesigner Natsai Audrey Chieza and her lab have been exploring bacteria called streptomyces coelicolor, which produce an antibiotic that ranges in color from blue to pink to purple. Through Project Coelicolor, her team developed “design-led microbiology protocols to dye silk scarves into different patterns and colors using this bacteria.” The protocols significantly reduce water use and harmful chemicals in the dyeing process. Watch a video about Chieza’s work here.

Photo by Aideal Hwa: Bacteria
15 Questions
What substitutes are better than the original?
What “replacement” are you most excited for?
Have you eaten any burgers made with lab-grown heme?
How long until Deep Tech improves upon cotton?
Parmesan?
Human touch?
Is this the future you’ve been expecting?
What about flying cars?
Will Deep Tech affect your industry?
Are there sectors that tech can’t improve?
Do you feel obsolete?
Will robots take over the world?
Or will our new masters be fungi?
Are you worried?
Do you know someone who is?
